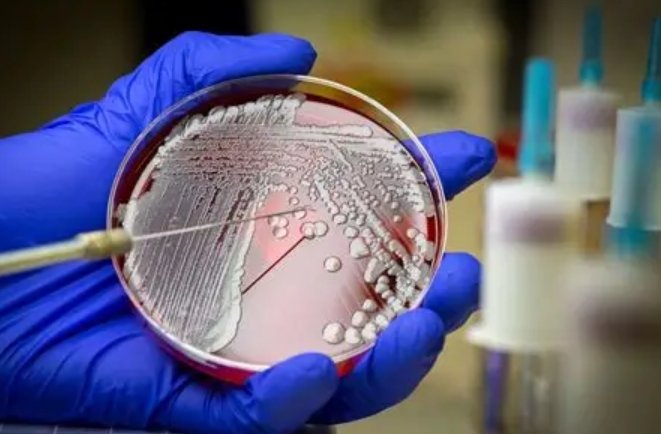

Ebola's dwindling incidence rate is having a direct impact on patient enrollment
Singapore: The steady decline in new ebola cases presents a formidable challenge to current and future clinical trials of investigational treatments for the disease, as it will be more difficult to recruit study participants and demonstrate efficacy, says Ms Daian Cheng, analyst, GlobalData.
According to Ms Cheng, analyst, GlobalData, Ebola's dwindling incidence rate is having a direct impact on patient enrollment for clinical trials of therapeutic agents, as evidenced by two studies for antiviral drugs favipiravir and brincidofovir.
Ms Cheng mentioned, "On January 30, Chimerix announced the decision to cease clinical investigations of its experimental Ebola drug, brincidofovir, as only a handful of participants were able to be recruited for a single-armed clinical trial in Liberia. The disease's decreasing incidence meant the study was unlikely to reach a convincing conclusion regarding the drug's efficacy."
In contrast, the analyst highlights the early success of anti-influenza drug, favipiravir (Avigan), in a clinical trial in Guinea. This product, currently marketed in Japan by FujiFilm Holdings Corporation, produced positive initial results, which encouraged the Guinea government to approve its use in a limited number of Ebola treatment centers.
"The favipiravir trial was not hindered by low patient recruitment, possibly due to its earlier start date compared with the brincidofovir trial. The fact that Guinea's local incidence rate was higher than Liberia's might also have contributed to its outcome. The information available from favipiravir's trial indicated that the drug could lower mortality rates and accelerate recovery in patients with low or moderate levels of Ebola virus in their blood. However, in the face of diminishing cases, its future use is uncertain," added Ms Cheng.
Ms Cheng further added that for pharmaceutical companies, the use of established antiviral agents certainly has its advantages, especially if a treatment can be positioned as an option for relieving an outbreak while still being useful and profitable for other indications when the outbreak subsides.